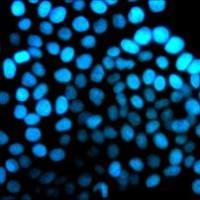
细胞实验外包

- 详细信息
- 技术资料
- 提供商:
上海达为科生物科技有限公司
- 服务名称:
代谢组学实验
| 品牌 | 其他品牌 | 产地类别 | 国产 |
|---|---|---|---|
| 应用领域 | 医疗卫生,生物产业,综合 |
代谢组学是继基因组学和蛋白质组学之后新进发展起来的一门学科,是系统生物学的重要组成部分。
通过组群指标分析,进行高通量检测和数据处理,研究生物体整体或组织细胞的动态代谢变化,特别是对内源代谢、遗传变异、环境变化乃至各种物质进入代谢系统的特征和影响的学科。
GC-MS
气相色谱-质谱联用(GC-MS)适宜分析小分子、易挥发、热稳定、能气化的化合物;用电子轰击方式(EI)得到的谱图,可与标准谱库对比。通过GC-MS分析技术,分析疾病患病组和正常组血清/尿液中的代谢成分,获得代谢组分的实验数据。利用数学分析方法寻找患病组和正常组中具有差异性的代谢组分,并建立未知样体分析模型。
LC-MS
液相色谱-质谱联用(LC-MS)可解决如下几方面的问题:不挥发性化合物分析测定;极性化合物的分析测定;热不稳定化合物的分析测定;大分子化合物(包括蛋白、多肽、多聚物等)的分析测定。通过LC-MS分析技术,分析疾病患病组和正常组血清/尿液中的代谢成分,获得代谢组分的实验数据。利用数学分析方法寻找患病组和正常组中具有差异性的代谢组分,并建立未知样体分析模型。

风险提示:丁香通仅作为第三方平台,为商家信息发布提供平台空间。用户咨询产品时请注意保护个人信息及财产安全,合理判断,谨慎选购商品,商家和用户对交易行为负责。对于医疗器械类产品,请先查证核实企业经营资质和医疗器械产品注册证情况。
技术资料暂无技术资料 索取技术资料
上海代谢组学实验
询价